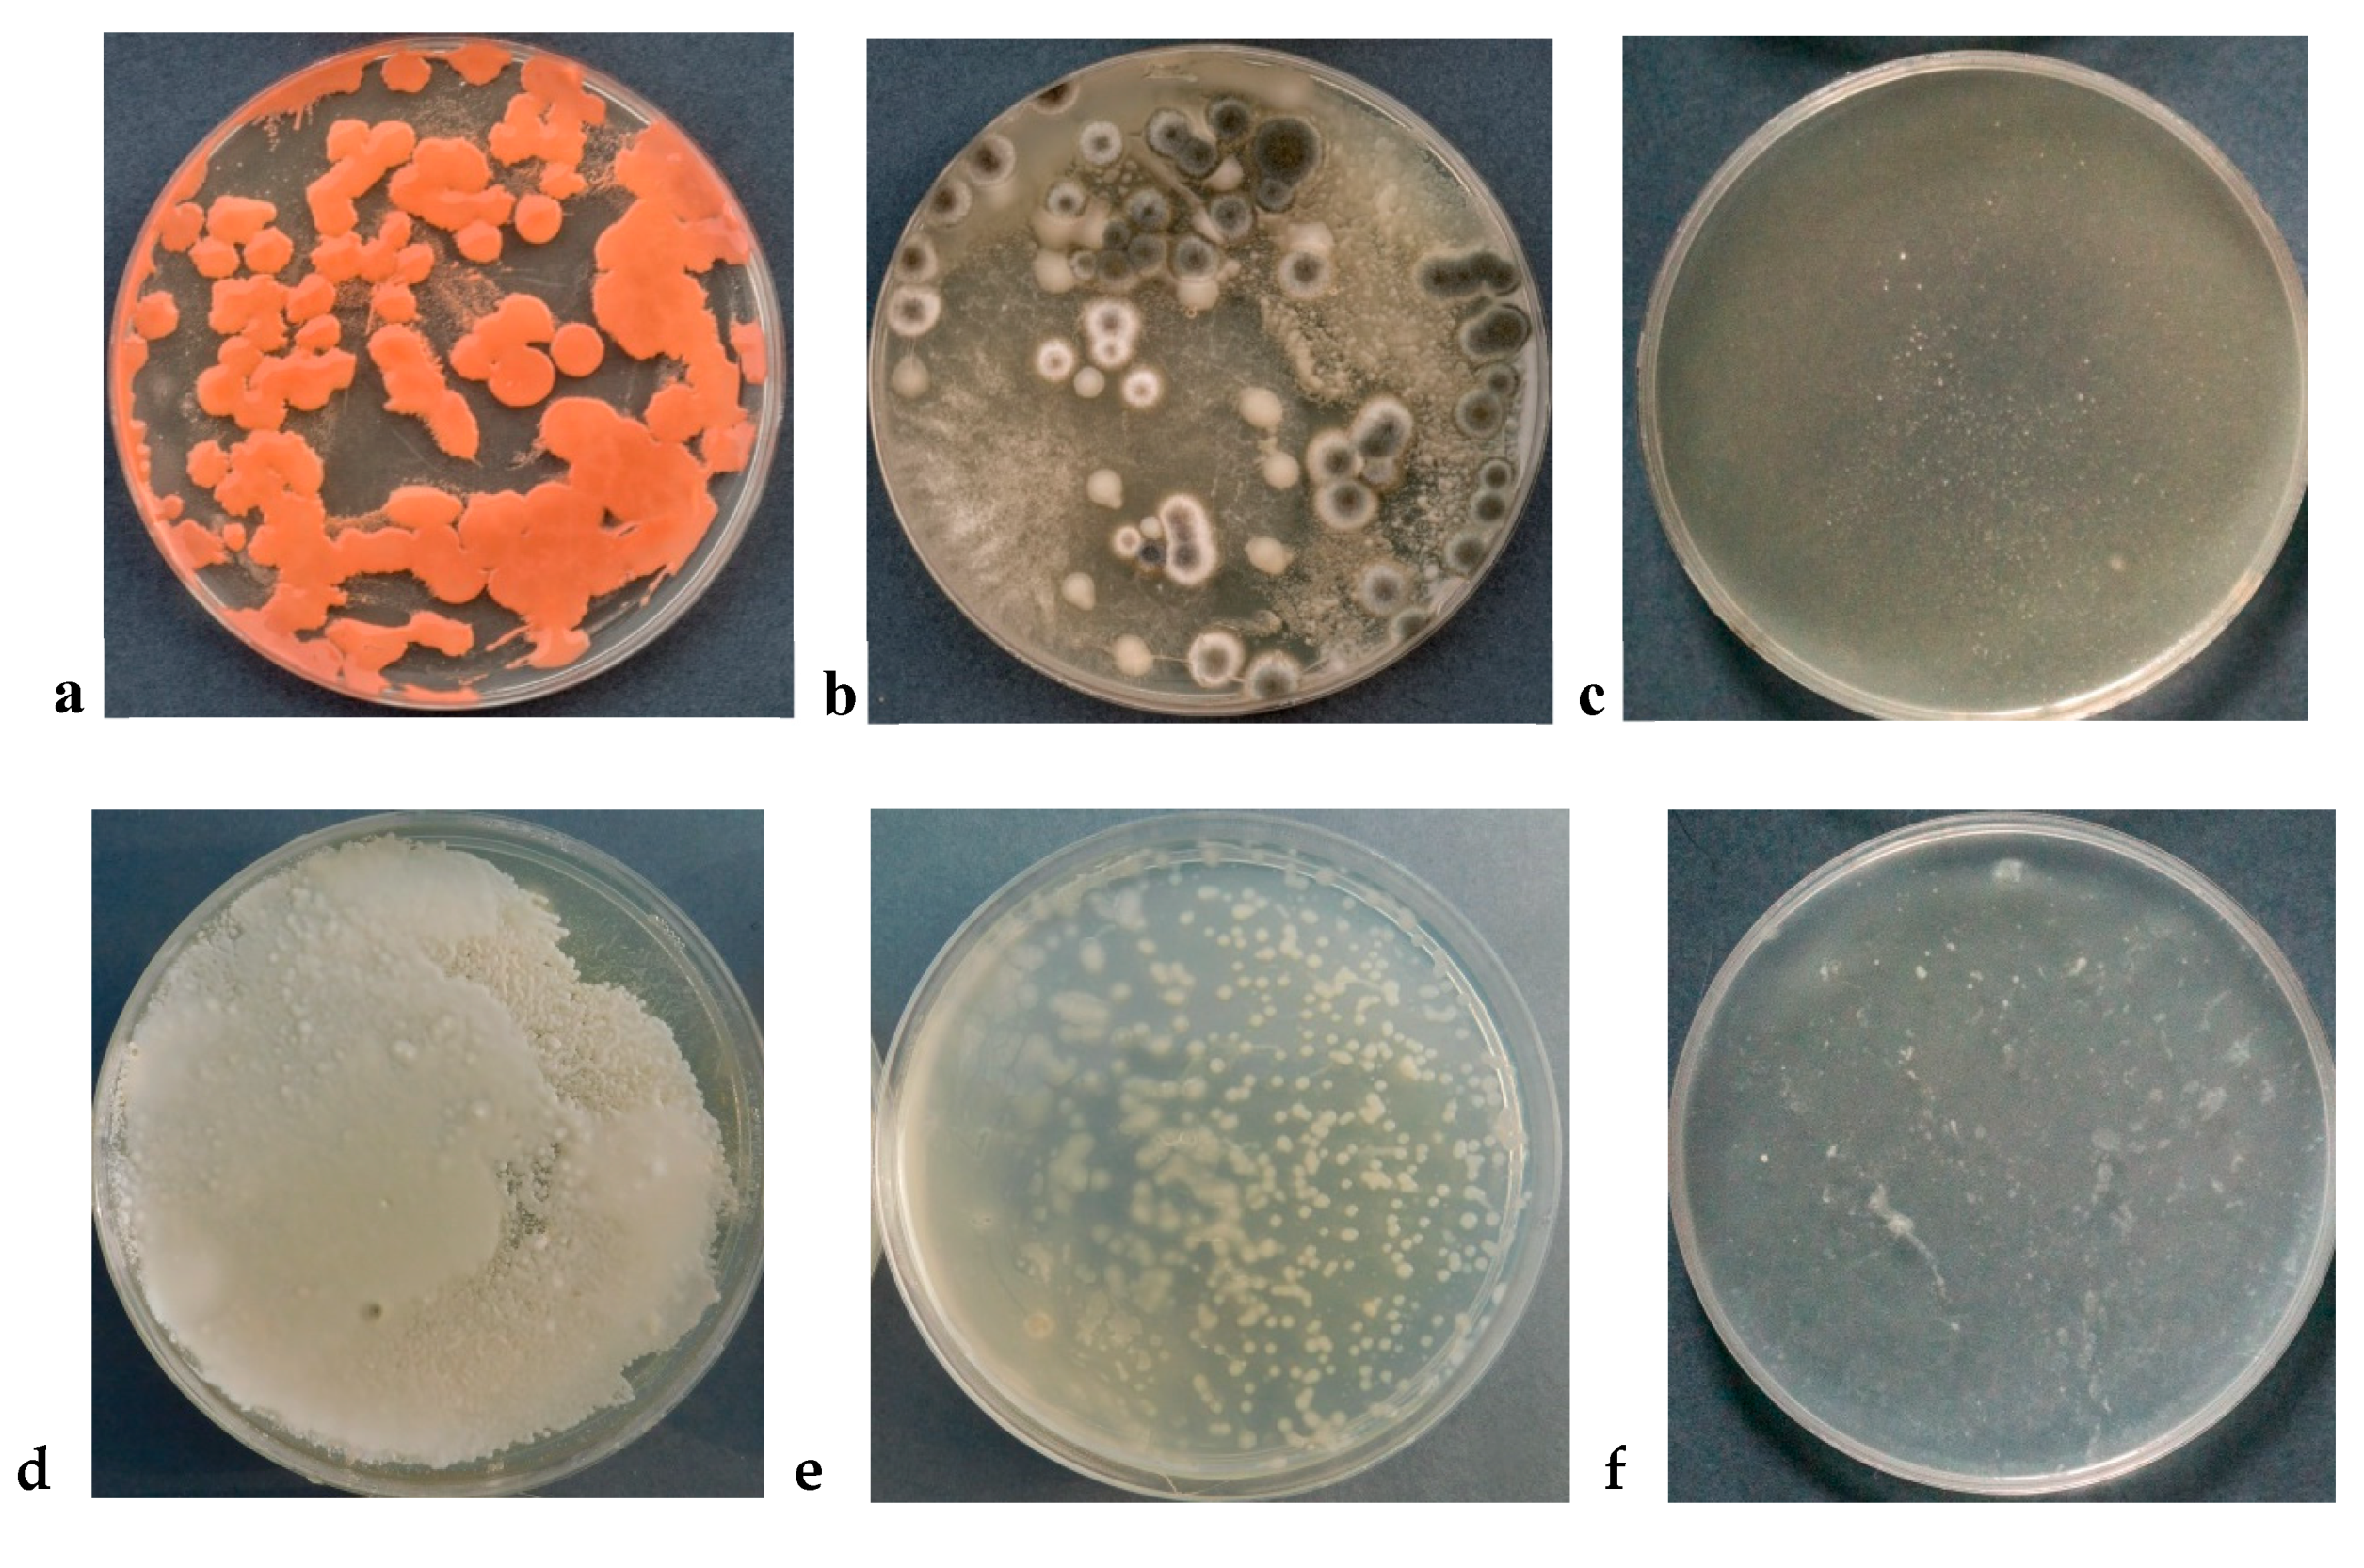
Coatings 10 00156 g005 Coatings 10 00156 g005

Efficiency of Novel Antimicrobial Coating Based on Iron Nanoparticles for Dairy Products’ Packaging
Abstract
1. Introduction
2. Materials and Methods
2.1. Materials
2.2. Preparation of Active PLA Film
2.3. Elemental Composition Assessment
2.4. Color and Gloss Testing
- 0 < TCD < 1—observer does not notice the difference in color;
- 1 < TCD < 2—only experienced observer can notice the difference in color;
- 2 < TCD < 3.5—inexperienced observer can also notice the difference;
- 3.5 < TCD < 5—clear difference in color is observable;
- 5 < TCD—observer notices two different colors of the analyzed sample.
2.5. Evaluation of the Antimicrobial Activity of ZVI and Application of Active Films
- -
- determination of psychrophilic microorganisms on the PCA medium (incubation at 20 °C ± 2 °C for 72 h);
- -
- determination of fungi on the Sabouraud medium (incubation at 20 °C ± 2 °C for 5–7 days).
3. Results
3.1. Composition and Structure of ZVI/PLA Films
3.2. Appearance and Optical Properties of ZVI/PLA Films
3.3. Antimicrobial Properties of ZVI/PLA Films
4. Discussion
5. Conclusions
6. Patents
Author Contributions
Funding
Conflicts of Interest
References
- Tichoniuk, M. Innovative packaging improving food quality and extending its shelf life. Pol. J. Commod. Sci. 2019, 1, 21–35. [Google Scholar] [CrossRef]
- Vanderroost, M.; Ragaert, P.; Devlieghere, F.; De Meulenaer, B. Intelligent food packaging: The next generation. Trends Food Sci. Techol. 2014, 39, 47–62. [Google Scholar] [CrossRef]
- Müller, P.; Schmid, M. Intelligent Packaging in the Food Sector: A Brief Overview. Foods 2019, 8, 16. [Google Scholar] [CrossRef]
- Schaefer, D.; Cheung, W.M. Smart Packaging: Opportunities and Challenges. Procedia CIRP 2018, 72, 1022–1027. [Google Scholar] [CrossRef]
- Bastarrachea, L.J.; Wong, D.E.; Roman, M.J.; Lin, Z.; Goddard, J.M. Active Packaging Coatings. Coatings 2015, 5, 771–791. [Google Scholar] [CrossRef]
- Poyatos-Racionero, E.; Ros-Lis, J.V.; Vivancos, J.L.; Martínez-Máñez, R. Recent advances on intelligent packaging as tools to reduce food waste. J. Clean Prod. 2018, 172, 3398–3409. [Google Scholar] [CrossRef]
- Yildirim, S.; Röcker, B.; Pettersen, M.K.; Nilsen-Nygaard, J.; Ayhan, Z.; Rutkaite, R.; Radusin, T.; Suminska, P.; Marcos, B.; Coma, V. Active Packaging Application for Food. Compr. Rev. Food Sci. Food Saf. 2018, 18, 165–199. [Google Scholar] [CrossRef]
- Realini, C.E.; Marcos, B. Active and intelligent packaging systems for a modern society. Meat. Sci. 2014, 98, 404–419. [Google Scholar] [CrossRef]
- Sofi, S.A.; Singh, J.; Rafiq, S.; Ashraf, U.; Dar, B.N.; Nayik, G.A. A Comprehensive Review on Antibacterial Packaging and its Use in Food Packaging. Curr. Nutr. Food Sci. 2017, 13, 1–8. [Google Scholar] [CrossRef]
- Socaciu, M.I.; Semeniuc, C.A.; Vodnar, D.C. Edible Films and Coatings for Fresh Fish Packaging: Focus on Quality Changes and Shelf-life Extension. Coatings 2018, 8, 366. [Google Scholar] [CrossRef]
- Malhotra, B.; Keshwani, A.; Kherkwal, H. Antimicrobial food packaging: Potential and pitfalls. Front. Microbiol. 2015, 6, 1–9. [Google Scholar] [CrossRef]
- Ramos, M.; Valdés, A.; Beltrán, A.; Garrigós, M.C. Gelatin-Based Films and Coatings for Food Packaging Applications. Coatings 2016, 6, 41. [Google Scholar] [CrossRef]
- Atarés, L.; Chiralt, A. Essential oils as additives in biodegradable films and coatings for active food packaging. Trends Food Sci. Technol. 2016, 48, 51–62. [Google Scholar] [CrossRef]
- Barbiroli, A.; Bonomi, F.; Capretti, G.; Iametti, S.; Manzoni, M.; Piergiovanni, L.; Rollini, M. Antimicrobial activity of lysozyme and lactoferrin incorporated in cellulose-based food packaging. Food Control 2012, 26, 387–392. [Google Scholar] [CrossRef]
- De Araújo, L.O.; Anaya, K.; Castellã Pergher, S.B. Synthesis of Antimicrobial Films Based on Low-Density Polyethylene (LDPE) and Zeolite a Containing Silver. Coatings 2019, 9, 786. [Google Scholar] [CrossRef]
- Soysal, Ç.; Bozkurt, H.; Dirican, E.; Güçlü, M.; Bozhüyük, E.D.; Uslu, A.E.; Kaya, S. Effect of antimicrobial packaging on physicochemical and microbial quality of chicken drumsticks. Food Control 2015, 54, 294–299. [Google Scholar] [CrossRef]
- Júnior, A.V.; Fronza, N.; Bortolini Foralosso, F.; Dezen, D.; Huber, E.; Zimnoch dos Santos, J.H.; Machado, F.R.A.; Novy Quadri, M.G. Biodegradable duo-functional active film: Antioxidant and antimicrobial actions for the conservation of beef. Food Bioprocess Technol. 2015, 8, 75–87. [Google Scholar] [CrossRef]
- Cozmuta, A.M.; Peter, A.; Cozmuta, L.M.; Camelia, N.; Crisan, L.; Baia, L.; Turila, A. Active packaging system based on Ag/TiO2 nanocomposite used for extending the shelf life of bread. Chemical and microbiological investigations. Packag. Technol. Sci. 2014, 28, 271–284. [Google Scholar] [CrossRef]
- Mlalila, N.; Kadam, D.M.; Swai, H.; Hilonga, A. Transformation of food packaging from passive to innovative via nanotechnology: Concepts and critiques. J. Food Sci. Technol. 2016, 53, 3395–3407. [Google Scholar] [CrossRef]
- Fierascu, I.; Fierascu, I.C.; Dinu-Pirvu, C.E.; Fierascu, R.C.; Anuta, V.; Velescu, B.S.; Jinga, M.; Jinga, V. A Short Overview of Recent Developments on Antimicrobial Coatings Based on Phytosynthesized Metal Nanoparticles. Coatings 2019, 9, 787. [Google Scholar] [CrossRef]
- Singh, S.; Gaikward, K.J.; Lee, Y.S. Antimicrobial and antioxidant properties of polyvinyl alcohol bio composite films containing seaweed extracted cellulose nano-crystal and basil leaves extract. Int. J. Biol. Macromol. 2018, 107, 1879–1887. [Google Scholar] [CrossRef]
- Hoseinnejad, M.; Jafari, S.M.; Katouzian, I. Inorganic and metal nanoparticles and their antimicrobial activity in food packaging applications. Crit. Rev. Microbiol. 2018, 44, 161–181. [Google Scholar] [CrossRef]
- Rhim, J.W.; Park, H.M.; Ha, C.S. Bio-nanocomposites for Food Packaging Applications. Prog. Polym. Sci. 2013, 38, 1629–1652. [Google Scholar] [CrossRef]
- Shankar, S.; Wang, L.F.; Rhim, J.W. Incorporation of zinc oxide nanoparticles improved the mechanical, water vapor barrier, UV-light barrier, and antibacterial properties of PLA-based nanocomposite films. Mat. Sci. Eng. C 2018, 93, 289–298. [Google Scholar] [CrossRef]
- Jamróz, E.; Kulawik, P.; Kopel, P. The Effect of Nanofillers on the Functional Properties of Biopolymer-Based Films: A Review. Polymers 2019, 11, 675. [Google Scholar] [CrossRef]
- Youssef, A.M.; El-Sayed, S.M.; Salama, H.H.; El-Sayed, H.S.; Dufresne, A. Evaluation of bionanocomposites as packaging material on properties of soft white cheese during storage period. Carbohydr. Polym. 2015, 132, 274–285. [Google Scholar] [CrossRef]
- Youssef, A.M.; El-Sayed, S.M.; El-Sayed, H.S.; Salama, H.S.; Dufresne, A. Enhancement of Egyptian soft white cheese shelf life using a novel chitosan/carboxymethyl cellulose/zinc oxide bionanocomposite film. Carbohydr. Polym. 2016, 151, 9–19. [Google Scholar] [CrossRef]
- Foltynowicz, Z. Nanoiron-Based Composite Oxygen Scavengers for Food Packaging. In Composites Materials for Food Packaging; Cirillo, G., Kozlowski, M.A., Spizzirri, U.G., Eds.; John Wiley & Sons Inc.: Hoboken, NJ, USA; Scrivener Publishing LLC: Beverly, MA, USA, 2018; pp. 209–234. ISBN 978-1-119-16020-5. [Google Scholar]
- Lee, C.; Kim, J.Y.; Lee, W.I.; Nelson, K.L.; Yoon, J.; Sedlak, D.L. Bactericidal Effect of Zero-Valent Iron Nanoparticles on Escherichia coli. Environ. Sci. Technol. 2008, 42, 4927–4933. [Google Scholar] [CrossRef]
- Diao, M.; Yao, M. Use of zero-valent iron nanoparticles in inactivating microbes. Water Res. 2009, 43, 5243–5251. [Google Scholar] [CrossRef]
- Dunca, T.V. Applications of nanotechnology in food packaging and food safety: Barrier materials, antimicrobials and sensors. J. Colloid Interface Sci. 2011, 363, 1–24. [Google Scholar] [CrossRef]
- Llorens, A.; Lloret, E.; Picouet, P.A.; Trbojevich, R.; Fernandez, A. Metallic-based micro and nanocomposites in food contact materials and active food packaging. Trends Food Sci. Technol. 2012, 24, 19–29. [Google Scholar] [CrossRef]
- Yan, W.; Lien, H.L.; Koel, B.E.; Zhang, W.X. Iron nanoparticles for environmental clean-up: Recent developments and future outlook. Environ. Sci. Process. Impacts 2013, 15, 63–77. [Google Scholar] [CrossRef] [PubMed]
- Theuer, R.C. Iron-fortified infant cereals. Food Rev. Int. 2008, 24, 277–310. [Google Scholar] [CrossRef]
- Sekhon, B.S. Food nanotechnology—An overview. Nanotechnol. Sci. Appl. 2010, 3, 1–15. [Google Scholar]
- Elsayed, H.H.; Al-Sherbini, A.A.M.; Abd-Elhady, E.E.; El Aziz Ahmed, K.A. Treatment of Anemia Progression via Magnetite and Folate Nanoparticles In Vivo. ISRN Nanotechnol. 2014, 2014, 287575. [Google Scholar] [CrossRef]
- Khalaj, M.-J.; Ahmadi, H.; Lesankhosh, R.; Khalaj, G. Study of physical and mechanical properties of polypropylene nanocomposites for food packaging application: Nano-clay modified with iron nanoparticles. Trends Food Sci. Technol. 2016, 51, 41–48. [Google Scholar] [CrossRef]
- Busolo, M.A.; Lagaron, J.M. Oxygen scavenging polyolefin nanocomposite films containing an iron modified kaolinite of interest in active food packaging applications. Innov. Food Sci. Emerg. 2012, 16, 211–217. [Google Scholar] [CrossRef]
- EFSA CEF Panel (EFSA Panel on Food Contact Materials, Enzymes, Flavorings and Processing Aids). Scientific Opinion on safety assessment of the active substance, iron (0) modified bentonite as oxygen absorber, for use in active food contact materials. EFSA J. 2013, 11, 3400. [Google Scholar] [CrossRef]
- EFSA CEF Panel (EFSA Panel on Food Contact Materials, Enzymes, Flavorings and Processing Aids). Scientific Opinion on safety assessment of the active substance, iron (0) modified kaolinite as oxygen absorber, for use in active food contact materials. EFSA J. 2013, 11, 3401. [Google Scholar] [CrossRef]
- Foltynowicz, Z.; Kozak, W.; Stoinska, J.; Urbanska, M.; Muc, K.; Dominiak, A.; Kublicka, K. Nanoiron-Based Oxygen Scavengers. Uniwersytet Ekonomiczny w Poznaniu. PCT/PL Patent 2011/050055, 29 December 2011. [Google Scholar]
- Foltynowicz, Z.; Kozak, W.; Stoinska, J.; Urbanska, M.; Muc, K.; Dominiak, A.; Kublicka, K. Nanoiron-based Oxygen Scavengers, Uniwersytet Ekonomiczny w Poznaniu. Patent EP2658666, 19 December 2018. [Google Scholar]
- Foltynowicz, Z.; Bardenshtein, B.; Sängerlaub, S.; Antvorskov, H.; Kozak, W. Nanoscale, zero valent iron particles for application as oxygen scavenger in food packaging. Food Packag. Shelf. Life 2017, 11, 74–83. [Google Scholar] [CrossRef]
- Mokrzycki, W.; Tatol, M. Color Difference ΔE—A Survey. Mach. Graph. Vis. 2011, 20, 383–411. [Google Scholar]

| Form of Antimicrobial Packaging | Active Substance(s) | Product Name (Company) |
|---|---|---|
| Antifungal coatings | Natamycin | Sanico® (Laboratories STANDA) |
| Component for a wrap/packaging foil | Silver | Bactiblock® (NanoBio Maters) |
| Component for a wrap/packaging foil | Silver | Irgaguard® (BASF) |
| Foils, wraps, cardboard packaging | Silver | Novaron® (Taogosei) |
| Foils, wraps, cardboard packaging | Silver zeolites | Aglon® (Aglon Technologies) |
| Foils, multi-layer materials | Inorganic components | Sanic Films® (Nanopack Technology & Packaging) |
| Laminated pads, packaging sheets | Sulphur dioxide | UvacyTM (Grapetek) |
| Sachets | Glucose oxidase | Bioka (Bioka Ltd.) |
| Sachets, foils, wraps | Chlorine dioxide | MicrogardieTM, MicrosphereTM (Bernard Technologies) |
| Sheets, labels, and foils with antibacterial and antifungal properties | Allyl isothiocyanate | Wasaouro® sheets (Mitsubishi-Kagagu Foods Co.) |
| CIE L*a*b* Color Parameters for | White Background | PLA | PLA with 1% ZVI | PLA with 3% ZVI | PLA with 5% ZVI |
|---|---|---|---|---|---|
| L | 96.93 ± 0.03 a | 98.42 ± 0.15 b | 97.59 ± 0.24 c | 85.31 ± 2.52 d | 80.26 ± 2.53 e |
| a | 0.15 ± 0.02 f | −0.89 ± 0.03 g | −1.00 ± 0.04 h | −0.88 ± 0.09 g | −0.89 ± 0.08 g |
| b | 2.13 ± 0.02 i | 4.79 ± 0.06 j | 5.78 ± 0.32 k | 9.08 ± 0.41 l | 8.06 ± 0.43 m |
| Color change (TCD values) of PLA and ZVI/PLA films rating against a white background | |||||
| TCD1 | – | 3.22 ± 0.20 | 3.88 ± 0.44 | 13.58 ± 2.59 | 17.73 ± 2.60 |
| Scale of color change | – | slightly noticeable | slightly noticeable | different color | very different color |
| Color change (TCD values) of ZVI/PLA films in relation to PLA film | |||||
| TCD2 | – | – | 1.30 ± 0.55 | 13.79 ± 2.71 | 18.45 ± 2.73 |
| Scale of color change | – | – | unnoticeable/slightly noticeable | different color | very different color |
| Selected Microorganism/PLA Film | Pure PLA | PLA + Iron Oxide (3%) | PLA + ZVI (1%) | PLA + ZVI (3%) |
|---|---|---|---|---|
| Geotrichum candidum | − | − | −/+ | + |
| Rhodotorula rubra | − | − | −/+ | + |
| Staphylococcus epidermidis | − | − | −/+ | + |
| Escherichia coli | − | − | −/+ | + |
| Bacillus subtilis | − | − | −/+ | + |
| Type of Packaging | Analyzed Microorganisms | Time of Cheese Storage at 4 °C +/−2 °C | ||||||
|---|---|---|---|---|---|---|---|---|
| 3 days | 1 week | 2 weeks | 3 weeks | 4 weeks | 5 weeks | 6 weeks | ||
| Polyolefin foil with PLA coating (packaging inner surface) | Bacteria | − | − | + | + | + | + | + |
| Fungi | − | − | + | + | + | + | + | |
| Polyolefin foil with PLA coating (product surface) | Bacteria | − | − | + | + | + | + | + |
| Fungi | − | − | + | + | + | + | + | |
| Polyolefin foil with PLA coating (product interior) | Bacteria | + | + | + | + | + | + | + |
| Fungi | − | − | − | − | − | + | + | |
| Packaging with ZVI/PLA coating (packaging inner surface) | Bacteria | − | − | − | − | − | − | − |
| Fungi | − | − | − | − | − | − | − | |
| Packaging with ZVI/PLA coating (product surface) | Bacteria | − | − | − | − | − | − | − |
| Fungi | − | − | − | − | − | − | − | |
| Packaging with ZVI/PLA coating (product interior) | Bacteria | + | + | + | + | + | + | + |
| Fungi | − | − | − | − | − | − | − | |
© 2020 by the authors. Licensee MDPI, Basel, Switzerland. This article is an open access article distributed under the terms and conditions of the Creative Commons Attribution (CC BY) license (http://creativecommons.org/licenses/by/4.0/).
Share and Cite
Ligaj, M.; Tichoniuk, M.; Cierpiszewski, R.; Foltynowicz, Z. Efficiency of Novel Antimicrobial Coating Based on Iron Nanoparticles for Dairy Products’ Packaging. Coatings 2020, 10, 156. https://doi.org/10.3390/coatings10020156
Ligaj M, Tichoniuk M, Cierpiszewski R, Foltynowicz Z. Efficiency of Novel Antimicrobial Coating Based on Iron Nanoparticles for Dairy Products’ Packaging. Coatings. 2020; 10(2):156. https://doi.org/10.3390/coatings10020156
Chicago/Turabian StyleLigaj, Marta, Mariusz Tichoniuk, Ryszard Cierpiszewski, and Zenon Foltynowicz. 2020. "Efficiency of Novel Antimicrobial Coating Based on Iron Nanoparticles for Dairy Products’ Packaging" Coatings 10, no. 2: 156. https://doi.org/10.3390/coatings10020156
APA StyleLigaj, M., Tichoniuk, M., Cierpiszewski, R., & Foltynowicz, Z. (2020). Efficiency of Novel Antimicrobial Coating Based on Iron Nanoparticles for Dairy Products’ Packaging. Coatings, 10(2), 156. https://doi.org/10.3390/coatings10020156

